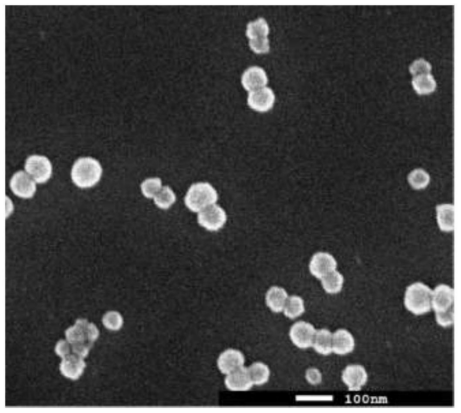
哑铃状二氧化硅磨料

在众多磨料体系中,硅溶胶(纳米二氧化硅颗粒在水或溶剂中的胶体分散体)因硬度适中、分散性好、对设备划伤风险较低等综合优势,在硅晶圆、二氧化硅、氮化硅等介电材料等的抛光上有着广泛的应用。。不过,半导体级应用对硅溶胶的要求极为苛刻,痕量金属杂质会扩散进入器件引发漏电或阈值电压漂移;颗粒尺寸不均或存在大颗粒会导致晶圆表面微划痕,直接降低良率;胶体稳定性差则造成抛光速率波动,影响批次一致性。因此,如何制备出同时满足“超高纯度、单分散粒径、可控形貌、长期稳定”的硅溶胶,成为材料界和半导体业界的共同挑战。

(来源:北京国瑞升)
电子级硅溶胶抛光液的制备难点
难点一:痕量金属杂质的去除
金属杂质是导致晶圆表面缺陷和器件失效的主要因素,Na、Fe、Al、Ca、Mg、Cu、Pb等金属离子会在抛光时残留在晶圆表面,破坏器件绝缘性能、引发漏电,或在高温制程中扩散至硅衬底,导致器件参数漂移。因此,用于芯片CMP抛光液的硅溶胶,其金属杂质含量通常要求控制在1 ppm以下,先进制程甚至要求单种金属杂质低于1 ppb。但在硅溶胶制备过程中,除了原料(硅粉、水玻璃、硅酸酯)本身自带微量金属,反应容器、管道、助剂也易引入污染,常规过滤、离子交换难以彻底去除ppb级杂质。
难点二:粒径单分散性的精确调控
采用粒径分布较宽的抛光液进行抛光时,其中大尺寸的氧化硅磨料容易在硅片表面产生划痕缺陷,并直接引发抛光速率波动或局部过抛现象。因此,磨料的粒径大小及其分散均匀性尤为关键。通常,半导体级硅溶胶的颗粒粒径需控制在10–50 nm范围内;部分高端制程(如5 nm及以下)则要求更精细的粒径控制,接近10–30 nm。然而,二氧化硅颗粒在生长过程中极易发生二次成核与团聚,难以实现真正的单分散。此外,在大规模生产中,温度、pH值、加料速率等参数的微小波动都会破坏粒径均匀性,这对生产工艺的精度提出了极高要求。
难点三:颗粒形貌的可控制备
常规使用的球形单分散硅溶胶作为抛光液磨料时,虽能获得较理想的表面质量,但球状二氧化硅易发生滚动且接触面积小,导致抛光效率较低。近年来,国外领先企业普遍致力于研发哑铃形、茧形、椭球形等非球形、无棱角且表面光滑的氧化硅磨粒。这类磨粒具有比表面积大、质地柔软、不易产生划痕等优点,在半导体CMP抛光中展现出广阔的应用前景。然而,受其特殊形貌的影响,该类磨粒的制备仍面临较大挑战。
哑铃状二氧化硅磨料(来源:网络)
难点四:长期稳定性的保障
长期稳定性则是硅溶胶实现工业化应用的基础,半导体抛光液需储存6~12个月以上,这就要求硅溶胶在宽pH(8~11)、高固含量(30%~40%)的条件下不凝胶、不分层、颗粒不长大,而其技术难点在于纳米颗粒表面能较高,易因静电斥力减弱、氢键作用发生团聚,同时温度变化、杂质离子污染会加速胶体失稳,且高固含量下稳定性控制难度呈指数级上升,需要通过表面改性、体系优化等技术手段提升其长期稳定性。
主流的电子级硅溶胶抛光液的制备
目前高纯硅溶胶的主流制备方法主要有离子交换法、单质硅水解法、溶胶-凝胶法(硅酸酯水解法)三种,三者在原料选择、产品纯度、粒径控制、生产成本等方面存在显著差异,适配不同层级的半导体抛光需求。
1、离子交换法
离子交换法又称水玻璃法,是目前技术最成熟、应用最广泛的制备方法,其以工业水玻璃(硅酸钠)为原料,经阳离子交换树脂去除Na⁺,经弱碱性阴离子交换树脂去除氯离子等杂质,得到稀硅溶胶,获得高纯度活性硅酸溶液。然后,加入稳定剂调节pH至8.5-10.5,通过晶核形成与粒子增长反应,制得单分散、粒径可控的硅溶胶,最后通过超滤或离心浓缩纯化。
![]()
离子交换法原理
该方法的优势在于适合大规模工业化生产,原料成本低, 粒径可调控至10~20nm,经深度纯化后,金属离子含量可控制在ppm级,满足中低端半导体抛光需求。但同时由于水玻璃原料含有大量金属杂质,提纯难度大,同时需要严格控制反应物浓度、pH值、温度等参数,避免出现粒径不均匀、凝胶化等问题,此外,该技术生产过程中还会产生大量含盐废水,树脂再生成本高,环保压力较大。
2、溶胶凝胶法
溶胶-凝胶法是以高纯正硅酸乙酯(TEOS)或正硅酸甲酯(TMOS)为硅源,在醇类溶剂中,经酸/碱催化水解、缩聚,生成SiO₂纳米颗粒,再经溶剂置换、浓缩得到高纯硅溶胶。在该过程中,通过精确调控反应条件,能够实现分子级掺杂,合成粒径均一、形貌可控且高纯度的二氧化硅纳米颗粒。
通常由于TEOS的成本相对较低,毒性较小,安全性较高,且水解速率相对较慢,反应更可控,是工业生产和实验室研究中更常用的硅源,而TMOS则水解速率非常快,反应剧烈,能更快地形成硅溶胶,有利于在短时间内获得高交联度的凝胶结构,但反应过程难以控制。
3、单质硅水解法
该技术以高纯度单质硅为原料,在无机或有机碱(如氢氧化钠)催化下,与纯水反应生成水合硅酸,经聚合形成硅溶胶。该技术生产的产品纯度取决于硅粉纯度,可制备出杂质含量极少的高纯硅溶胶,同时,SiO2胶粒的粒径、粘度、pH值、密度、纯度等指标也相对于其他方法更容易控制,但形貌控制难度较大,且存在氢气爆炸风险。

单质硅水解法流程
小结
从痕量金属杂质的极致去除,到单分散粒径与可控形貌的精准调控,再到长期储存稳定性的保障,电子级高纯硅溶胶抛光液的每一道技术难关都直接关系着半导体CMP工艺的良率与可靠性。当前,离子交换法、溶胶-凝胶法和单质硅水解法各有优劣:离子交换法成本低、工艺成熟,但提纯与环保压力较大;溶胶-凝胶法可实现高纯度与形貌可控,但原料成本较高;单质硅水解法产品纯度高,但存在安全风险与形貌控制难题。未来,随着芯片制程向更低节点演进,硅溶胶的制备除了要突破ppb级金属杂质控制,更要往非球形磨粒的可控制备上发展。
粉体圈Corange整理